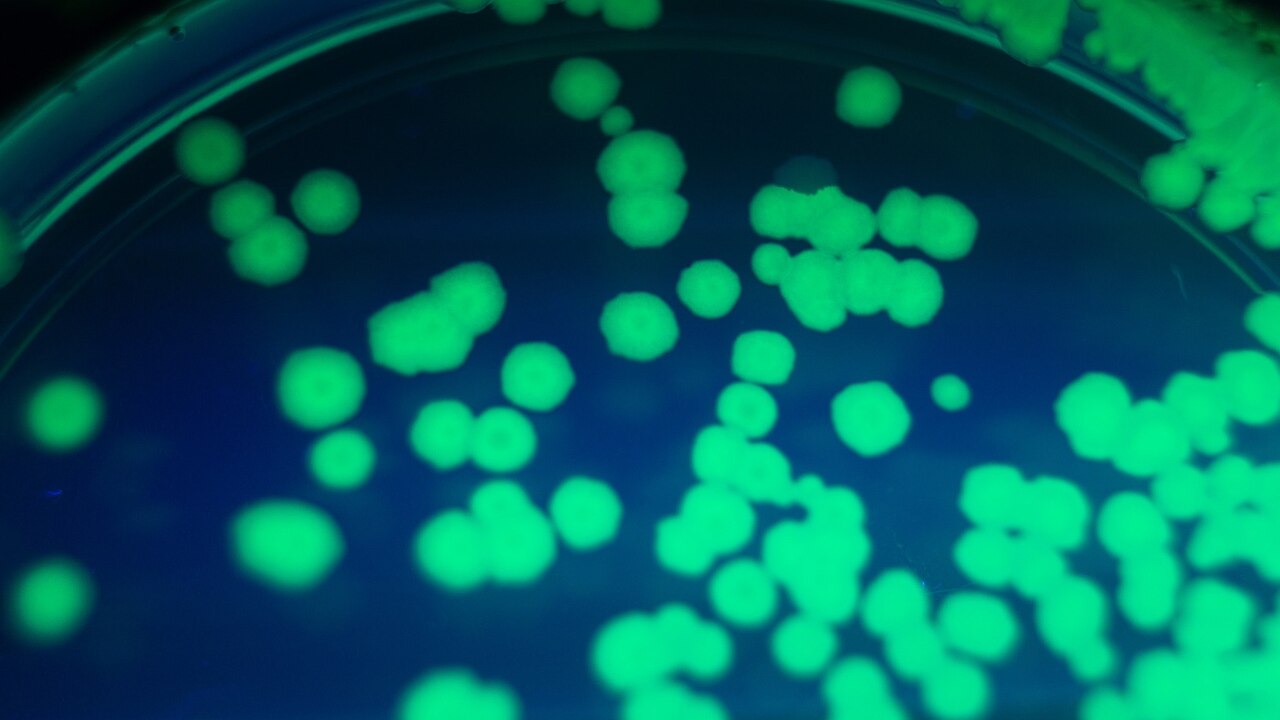

Ген GFP и его использование в бактериях E. coli











.jpg)

:quality(90)/images.vogel.de/vogelonline/bdb/1024300/1024349/original.jpg)























Раздел: Фотоархив познания